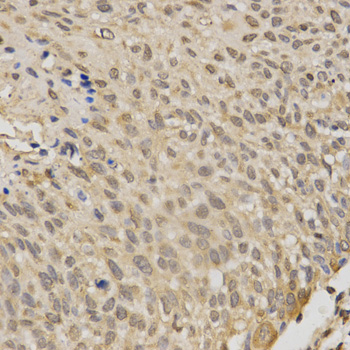
A2122: image 2
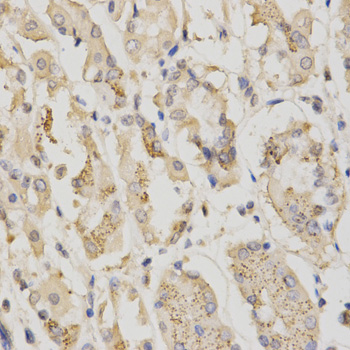
A2122: image 3

For quotations, please use our online quotation form, and you may also contact us by
sales@neoscientific.com
+1-888.733.6849
+1-617.299.7367 (Int’l)
+1-888.733.6849
+1-617.299.7367 (Int’l)
| Reactivity | Human Mouse Rat |
| Tested applications | WB IHC IF |
| Recommended Dilution | WB 1:500 - 1:2000 IHC 1:50 - 1:200 IF 1:50 - 1:200 |
| Calculated MW | 49kDa |
| Observed MW | Refer to Figures |
| Immunogen | Recombinant protein of human STK11 |
| Storage Buffer | Store at -20℃. Avoid freeze / thaw cycles. Buffer: PBS with 0.02% sodium azide, 50% glycerol, pH7.3. |
| Concentration | bc |
| Synonym | LKB1; PJS; |

Western blot analysis of extracts of various cell lines, using STK11 antibody.
Immunohistochemistry of paraffin-embedded human esophageal cancer using STK11 antibody at dilution of 1:200 (x400 lens)
Immunohistochemistry of paraffin-embedded human stomach using STK11 antibody at dilution of 1:200 (x400 lens)

Immunofluorescence analysis of MCF7 cell using STK11 antibody. Blue: DAPI for nuclear staining.
LKB1 (STK11) is a serine/threonine kinase and tumor suppressor that helps control cell structure, apoptosis and energy homeostasis through regulation of numerous downstream kinases (1,2). A cytosolic protein complex comprised of LKB1, putative kinase STRAD, and the MO25 scaffold protein, activates both AMP-activated protein kinase (AMPK) and several AMPK-related kinases (3). AMPK plays a predominant role as the master regulator of cellular energy homeostasis, controlling downstream effectors that regulate cell growth and apoptosis in response to cellular ATP concentrations (4). LKB1 appears to be phosphorylated in cells at several sites, including human LKB1 at Ser31/325/428 and Thr189/336/363 (5).Mutation in the corresponding LKB1 gene causes Peutz-Jeghers syndrome (PJS), an autosomal dominant disorder characterized by benign GI tract polyps and dark skin lesions of the mouth, hands and feet (6). A variety of other LKB1 gene mutations have been associated with the formation of sporadic cancers in several tissues (7).
N/A